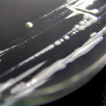
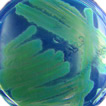
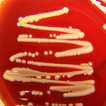

| Unsere Leistungen richten sich an Krankenhäuser, Zentren zum ambulanten Operieren, Arztpraxen, Geburtshäuser und andere medizinische Einrichtungen, lebensmittelverarbeitende Betriebe, Hotels und Gaststätten, Hausverwaltungen, Gartenkolonien, Sportstätten, Altenheime und Privathaushalte und andere. | |
     |
|
| Leistungen für medizinische Einrichtungen | Überprüfung der Desinfektionsleistung von Reinigungs- und Desinfektionsgeräten (RDG) zur Aufbereitung von: chirurgischen Instrumenten, Utensilien aus Anästhesie und und Intensivmedizin, Entsorgungs- Speise und Instrumentencontainern, OP-Schuhen, Bettgestellen und Nachttischen, Steckbecken, Endoskopen Kontrolle der Händedesinfektion Überprüfung von Krankenhauswäschereien Überprüfung der Dampfdesinfektion bei 105 °C nach DIN 5894 Sterilitätsprüfung nach dem europäischen Arzneibuch Untersuchung von Dialysierflüssigkeit Überprüfung von Sterilwerkbänken (laminar-air flow) nach EU-Leitfaden |
|
|
| Wasseruntersuchungen |
Hygienisch-mikrobiologische Untersuchung von Trink- und Tafelwasser nach der Trinkwasserverordnung 2001 Untersuchung von Schwimm- und Badewasser nach DIN 19643 Nachweis von Legionellen und Pseudomonas aeruginosa aus wasserführenden Systemen, Wasserleitungen, Zahnarzteinheiten |
| Untersuchungen von Klimaanlagen | Überprüfung von Raumlufttechnischen Anlagen (RLT) gem. DIN 1946 Teil 4 |
|
|
| Allgemeine Hygieneuntersuchungen | Umgebungsuntersuchungen mittels Abstrich und Abklatschprobe Kontaminationsprüfung von Arbeitsflächen und Gegenständen Überprüfung von Küchen |
| Desinfektionsmittelprüfungen |
Gutachtenerstellung gemäß VAH Prüfung von Desinfektionsmitteln für die Flächendesinfektion, Instrumentendesinfektion, Händedesinfektion Wirksamkeitsprüfung antibakterieller Oberflächen und Textilien |
© 2008 Hygiene-Institut Berlin Search Care GmbH. Alle Rechte vorbehalten. | Impressum | Nutzungsbedingungen


